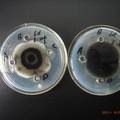

基本信息
- 项目名称:
- 一株生防放线菌抗菌谱测定及发酵条件优化
- 来源:
- 第十二届“挑战杯”省赛作品
- 小类:
- 生命科学
- 大类:
- 自然科学类学术论文
- 简介:
- 本实验以黑龙江八一农垦大学微生物实验室保存的一株具有拮抗活性的生防放线菌E为研究材料,利用其与不同病原微生物的对峙实验研究了该菌株的抑菌谱,通过管碟法对其拮抗物质产生的最适发酵条件进行优化。
- 详细介绍:
- 本实验以黑龙江八一农垦大学微生物实验室保存的一株具有拮抗活性的生防放线菌E为研究材料,利用其与不同病原微生物的对峙实验研究了该菌株的抑菌谱,通过管碟法对其拮抗物质产生的最适发酵条件进行优化。结果表明:该菌株对供试病原菌均有不同程度的抑制作用,是一株抗菌谱较广的生防菌;该菌株在28℃、185r/min振荡培养时,在7、8、9d时产生的拮抗物质抑菌效果较强,且该抑菌成分随时间延长活性较稳定;在相同培养天数下,马铃薯蔗糖(PD)比高氏液体培养基产生的拮抗物质抑菌能力更强;在高氏培养基中添加有机氮源能有效促进放线菌E的生长及抑菌活性物质的生成。
作品专业信息
撰写目的和基本思路
- 目的:为研究生防放线菌的抑菌能力及其发酵条件优化,为开发新的广谱型农业抗菌生物农药发掘新的放线菌菌源及为开发放线菌生物农药资源提供理论和实验依据。 基本思路:对一株未确定菌种的生防放线菌进行抗菌谱测定,然后对其发酵条件进行优化,以研究该放线菌的最适发酵条件,以及发酵产物对病原菌的抑菌能力的测定。
科学性、先进性及独特之处
- 本实验借鉴了不少前人的研究成果,并参考了前人的研究方法,结合本实验室现有的条件,对一些实验方案进行了改进,如在对该放线菌的最适发酵条件初步确认一步,我们采用了琼脂块法,将培养放线菌的不同培养基无菌琼脂块来进行实验。以及用管碟法研究并确定了拮抗放线菌的抑菌物质产生与发酵时间的关系,该法经实验结果证明具有较高的可靠性和可行性,且未在文献上报道过,属首创的实验方法。
应用价值和现实意义
- 本实验研究了一株生防放线菌的抗菌谱和最适发酵条件,以及抑菌活性物质浓度随时间变化规律,其结果显示,该株放线菌的抑菌谱很广,在生物农药方面有很大的利用和开发价值。并且本实验对发酵条件的优化和产物浓度随时间变化规律的研究成果还可为该菌的工业化发酵生产提供理论和实验依据,有助于更好地开发该株放线菌资源。
学术论文摘要
- 本实验以黑龙江八一农垦大学微生物实验室保存的一株具有拮抗活性的生防放线菌E为研究材料,利用其与不同病原微生物的对峙实验研究了该菌株的抑菌谱,通过管碟法对其拮抗物质产生的最适发酵条件进行优化。结果表明:该菌株对供试病原菌均有不同程度的抑制作用,是一株抗菌谱较广的生防菌;该菌株在28℃、185r/min振荡培养时,在7、8、9d时产生的拮抗物质抑菌效果较强,且该抑菌成分随时间延长活性较稳定;在相同培养天数下,马铃薯蔗糖(PD)比高氏液体培养基产生的拮抗物质抑菌能力更强;在高氏培养基中添加有机氮源能有效促进放线菌E的生长及抑菌活性物质的生成。
获奖情况
- 未曾发表
鉴定结果
- 待鉴定
参考文献
- [1] 雷娟, 段静波, 马寒, 等. 一株抗青枯假单胞菌放线菌的筛选、鉴定及发酵条件优化[J].应用与环境生物学报, 2010, 16(1): 79-83 [2] 王家琛, 蒋继志.放线菌MC-15发酵产物的稳定性及对马铃薯晚疫病的防治[J]. 中国农学通报, 2010, 26(19): 253-257 [3] 王小琴,龚斌,朱薇玲,等. 放线菌327#的发酵培养基筛选及培养条件优化[J].中国酿造-2010年10期 [4] 张茹萍,郑洪波,贾春燕,等. 放线菌菌株97发酵液中活性代谢产物的抑菌作用及稳定性测定[J].中国农学通报-2010年18期 [5] 张攀,陈林,彭玉梅,等. 缙云山土壤拮抗放线菌的分离、筛选与发酵条件优化[J]. 河南农业科学-2010年8期 [6] 李婵,刘双清,彭可为,等. 放线菌株SJY56的分离鉴定及其抗菌活性的初步研究[J]. 湖南农业科学-2010年3期 [7] 隋丽,徐文静,杜茜,等. 放线菌769防治水稻稻瘟病的发酵条件研究[J].吉林农业科学-2010年4期 [8] 郭小芳,宗兆锋. 5株生防放线菌发酵条件初探[J].西藏大学学报-2010年3期 [9] 陈雯舒,曹远银,孙仲桂,等. 放线菌C-2发酵产物对草莓和黄瓜白粉病的生防效果[J]. 江苏农业科学-2010年3期 [10] 杨春平,谢津,陈华保,等. 苦皮藤内生放线菌YDG17菌株产抑菌活性物质发酵条件优化[J].江苏农业科学-2010年3期
同类课题研究水平概述
- 放线菌因菌落呈放线状而得名,它隶属于原核生物类群,在自然界中分布广泛。由于其能产生化学结构多样的具有抗生素活性的代谢产物而广泛应用于农业植物病害的生物防治中。不同放线菌的拮抗机理及抑菌范围不尽相同,因而国内外针对不同的放线菌菌株开展了大量的研究工作,以探讨不同放线菌的抑菌能力及抑菌范围。 拮抗放线菌的生防作用多种多样,如重寄生作用、竞争作用、抗生素的作用、酶及其它次生代谢物的作用及诱导抗性等。利用放线菌的代谢产物开发成微生物源农药进而应用其防治植物病害是其在生物防治中的主要形式之一,实践表明,放线菌的代谢产物—农用抗生素在农业上的应用为农作物增产、增收做出了重大贡献。 放线菌发酵过程的优化改良,主要包括发酵培养基的改良和发酵条件的优化。国内外的研究结果表明:不同的放线菌在发酵过程中可产生不同的代谢产物,即使同种放线菌在不同的发酵培养基中也可产生不同的代谢产物,且培养基的组成和元素的配比等对菌体生长及抗生素的产生都有相当大的影响。因而如何利用发酵过程优化抗生素生产,对于我国的农用抗生素生产意义深远。 本研究主要针对实验室保存的拮抗放线菌,通过对峙培养确定其抑菌谱;通过改变培养基及培养基中的添加物明确不同培养条件对代谢产物抑菌能力的影响;在后续工作中利用现有条件对高效拮抗放线菌菌种进行鉴定,进一步优化发酵条件及分离与鉴定代谢产物中的活性抑菌成分。